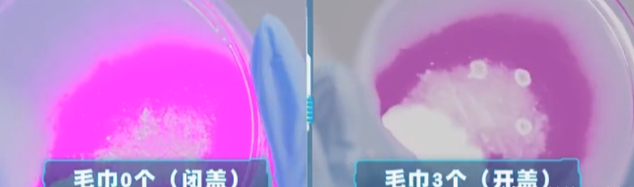
冲马桶一定要盖马桶盖!实验告诉你,冲马桶不盖马桶盖风险有多大

冲马桶一定要盖马桶盖!实验告诉你,冲马桶不盖马桶盖风险有多大

文章图片

文章图片

文章图片
文章图片

文章图片

冲马桶时 , 你会盖上马桶盖再冲 , 还是敞开式直接冲?或许看完这篇文章 , 会让你有新的改观 。
人类的粪便之中 , 除了有食物残渣 , 脱落的细胞之外 , 还有许多细菌、病毒甚至是寄生虫等生物 , 它们身影非常小 , 肉眼无法看到 , 但它们却可能会在我们冲马桶时 , 而飘落到卫生间的角落之中 。
有人曾经利用干冰做过一次冲马桶实验 , 干冰的气体密度比空气大 , 所以一般情况下 , 干冰所产生的烟雾应该会在底层空间 。
工作人员利用干冰模拟马桶内的微生物们 , 然后敞开马桶盖冲水 , 结果马桶盖冲水时产生的气流带动了干冰烟雾向上飘散 , 其中越是靠近马桶口 , 干冰烟雾越浓 , 这也说明身高越矮 , 受到的影响越大 。
其中在冲马桶过程中 , 马桶水流会将一部分水汽混合着粪便颗粒或者是尿液被冲入到了马桶上方 , 以气溶胶的形式停留在空中 。
2014年时 , 有人利用紫外线显色颜料 , 与高速摄像机 , 将开着马桶盖冲水的一瞬间拍摄了下来 。
结果发现 , 马桶内的污染物竟然可以喷溅到约60厘米之外的地面上;从马桶中飞出来的微小水滴 , 也可以喷射到了约1.8米外的牙刷上 。
央视节目《加油向未来》中 , 也做过一次盖马桶盖和不盖马桶盖的实验 , 为了保证实验的严谨性 , 两名工作人员身穿无菌服 , 处于无菌的房间内 , 然后将一种添加了荧光标记的细菌倒入到马桶内 , 然后在马桶周围的物体上 , 放了5个细菌培养皿 。
首先是模拟的不盖马桶盖的后果 , 结果显示在不盖马桶盖的实验中 , 所有的培养皿中都出现了标记细菌 , 而且数量还不少 。
第二次模拟的是盖马桶盖的后果 , 结果显示盖上马桶盖之后 , 虽然也有细菌溅出 , 但数量明显要少 , 而且有许多培养皿中都没有发现细菌 。
通过以上实验 , 可以看出盖上马桶盖 , 可以有效减少细菌溅出的风险 。
除此之外 , 马桶的不同也会影响要不要盖马桶盖 , 如果你家所使用的是虹吸式马桶 , 那么盖不盖马桶盖的印象并不大 。
不盖马桶盖会传播疾病吗?既然不盖马桶盖会让马桶内的污染物溅出 , 而马桶内的污染物中 , 又有许多是细菌、病毒等微生物 , 那长期处于这样的环境之下 , 人类会生病吗?
其实 , 不盖马桶盖虽然会喷出较多的污染物 , 但并不一定会引起人们生命 。
首先是因为微生物种类数量众多 , 但是大多数微生物对人类无害 , 只有极少数微生物能够感染人类 , 造成人类患病 。
其次 , 即便是致病菌 , 或者是人类易感病毒 , 也要达到一定的数量才能够感染人类 , 少量的病毒或者细菌进入人体后 , 将会被人体的免疫细胞清理出去 , 从而保证了人类的健康 。
- 为啥许多农村房子门口都挂着一个镜子
- 带阁楼的新房,以黑白灰为主基调,装饰出一个轻奢、高雅的家
- 发现一个53岁阿姨的家,那叫一个高级,分享给大家看看,羡慕极了
- 难怪装修户型一定要改造!看了她90㎡家后,才知道有多巧妙
- 苹果笔记本价格表-苹果笔记本电脑价格一览表
- 一个家是否上档次,关键看这4个“地方”!可惜很多人都不懂
- 卫生间镜子有讲究,一不小心就放错了
- 晒晒准备入住的280平新房,装修耗时一年,花费60万,够不够豪?
- 119㎡现代风三居室,客餐厅一体化的设计效果不一般,瞬间爱了
- 现代小别墅突出的就是一个通透,把采光和视野做到了极致
特别声明:本站内容均来自网友提供或互联网,仅供参考,请勿用于商业和其他非法用途。如果侵犯了您的权益请与我们联系,我们将在24小时内删除。
